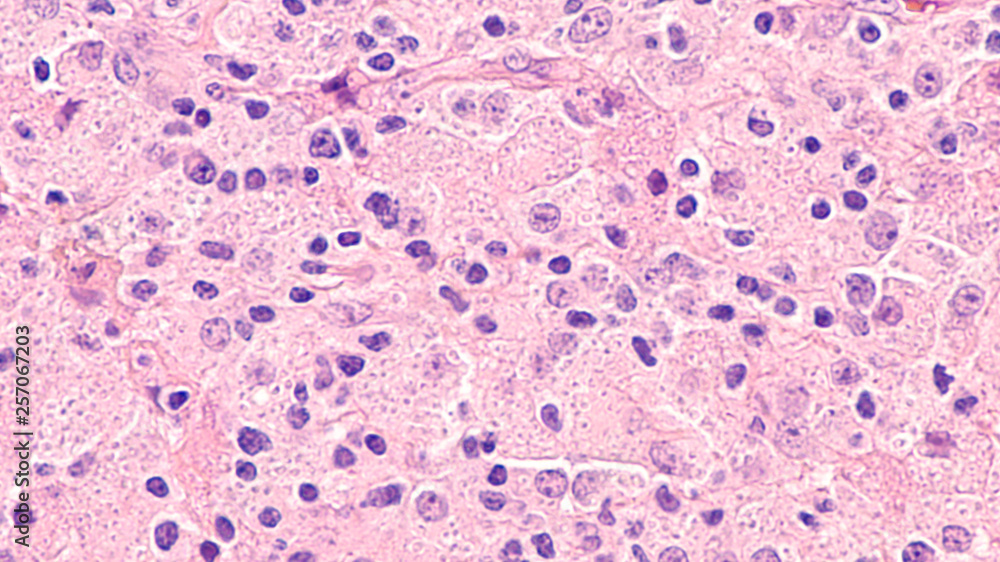
Histoplasma Capsulatum

Histoplasma capsulatum è un fungo Ascomycota, agente eziologico dell'istoplasmosi; cresce soprattutto in aree contaminate da escrementi di pipistrelli e di uccelli. Questo fungo è un fungo dimorfico.
Storia
L'histoplasma è stato scoperto nel 1905 da Darling, l'infezione invece è stata studiata soltanto nel 1930: prima di allora la malattia veniva confusa con la tubercolosi.
Infezione nell'uomo
Il fungo penetra nell'ospite umano attraverso l'inalazione di conidi o frammenti di ife; passando nei polmoni vengono fagocitati dai macrofagi polmonari e si convertono in lieviti (in quanto fungo dimorfico), così in grado di replicarsi all'interno dei macrofagi stessi.
Nell'ospite il cui sistema immunitario non è compromesso i macrofagi acquistano immunità e limitano l'infezione; in condizione di immunocompromissione l'infezione si diffonde e può diventare grave.
Il 5% delle infezioni sono asintomatiche e si risolvono spontaneamente, con una sindrome che somiglia ad una semplice influenza; in casi dove vi sono già problemi polmonari, può provocare lesioni anche distruttive del tessuto polmonare.
Note
Voci correlate
- Istoplasmosi
Altri progetti
- Wikimedia Commons contiene immagini o altri file su Histoplasma capsulatum
- Wikispecies contiene informazioni su Histoplasma capsulatum
Collegamenti esterni
- (EN) Histoplasma capsulatum, su Enciclopedia Britannica, Encyclopædia Britannica, Inc.